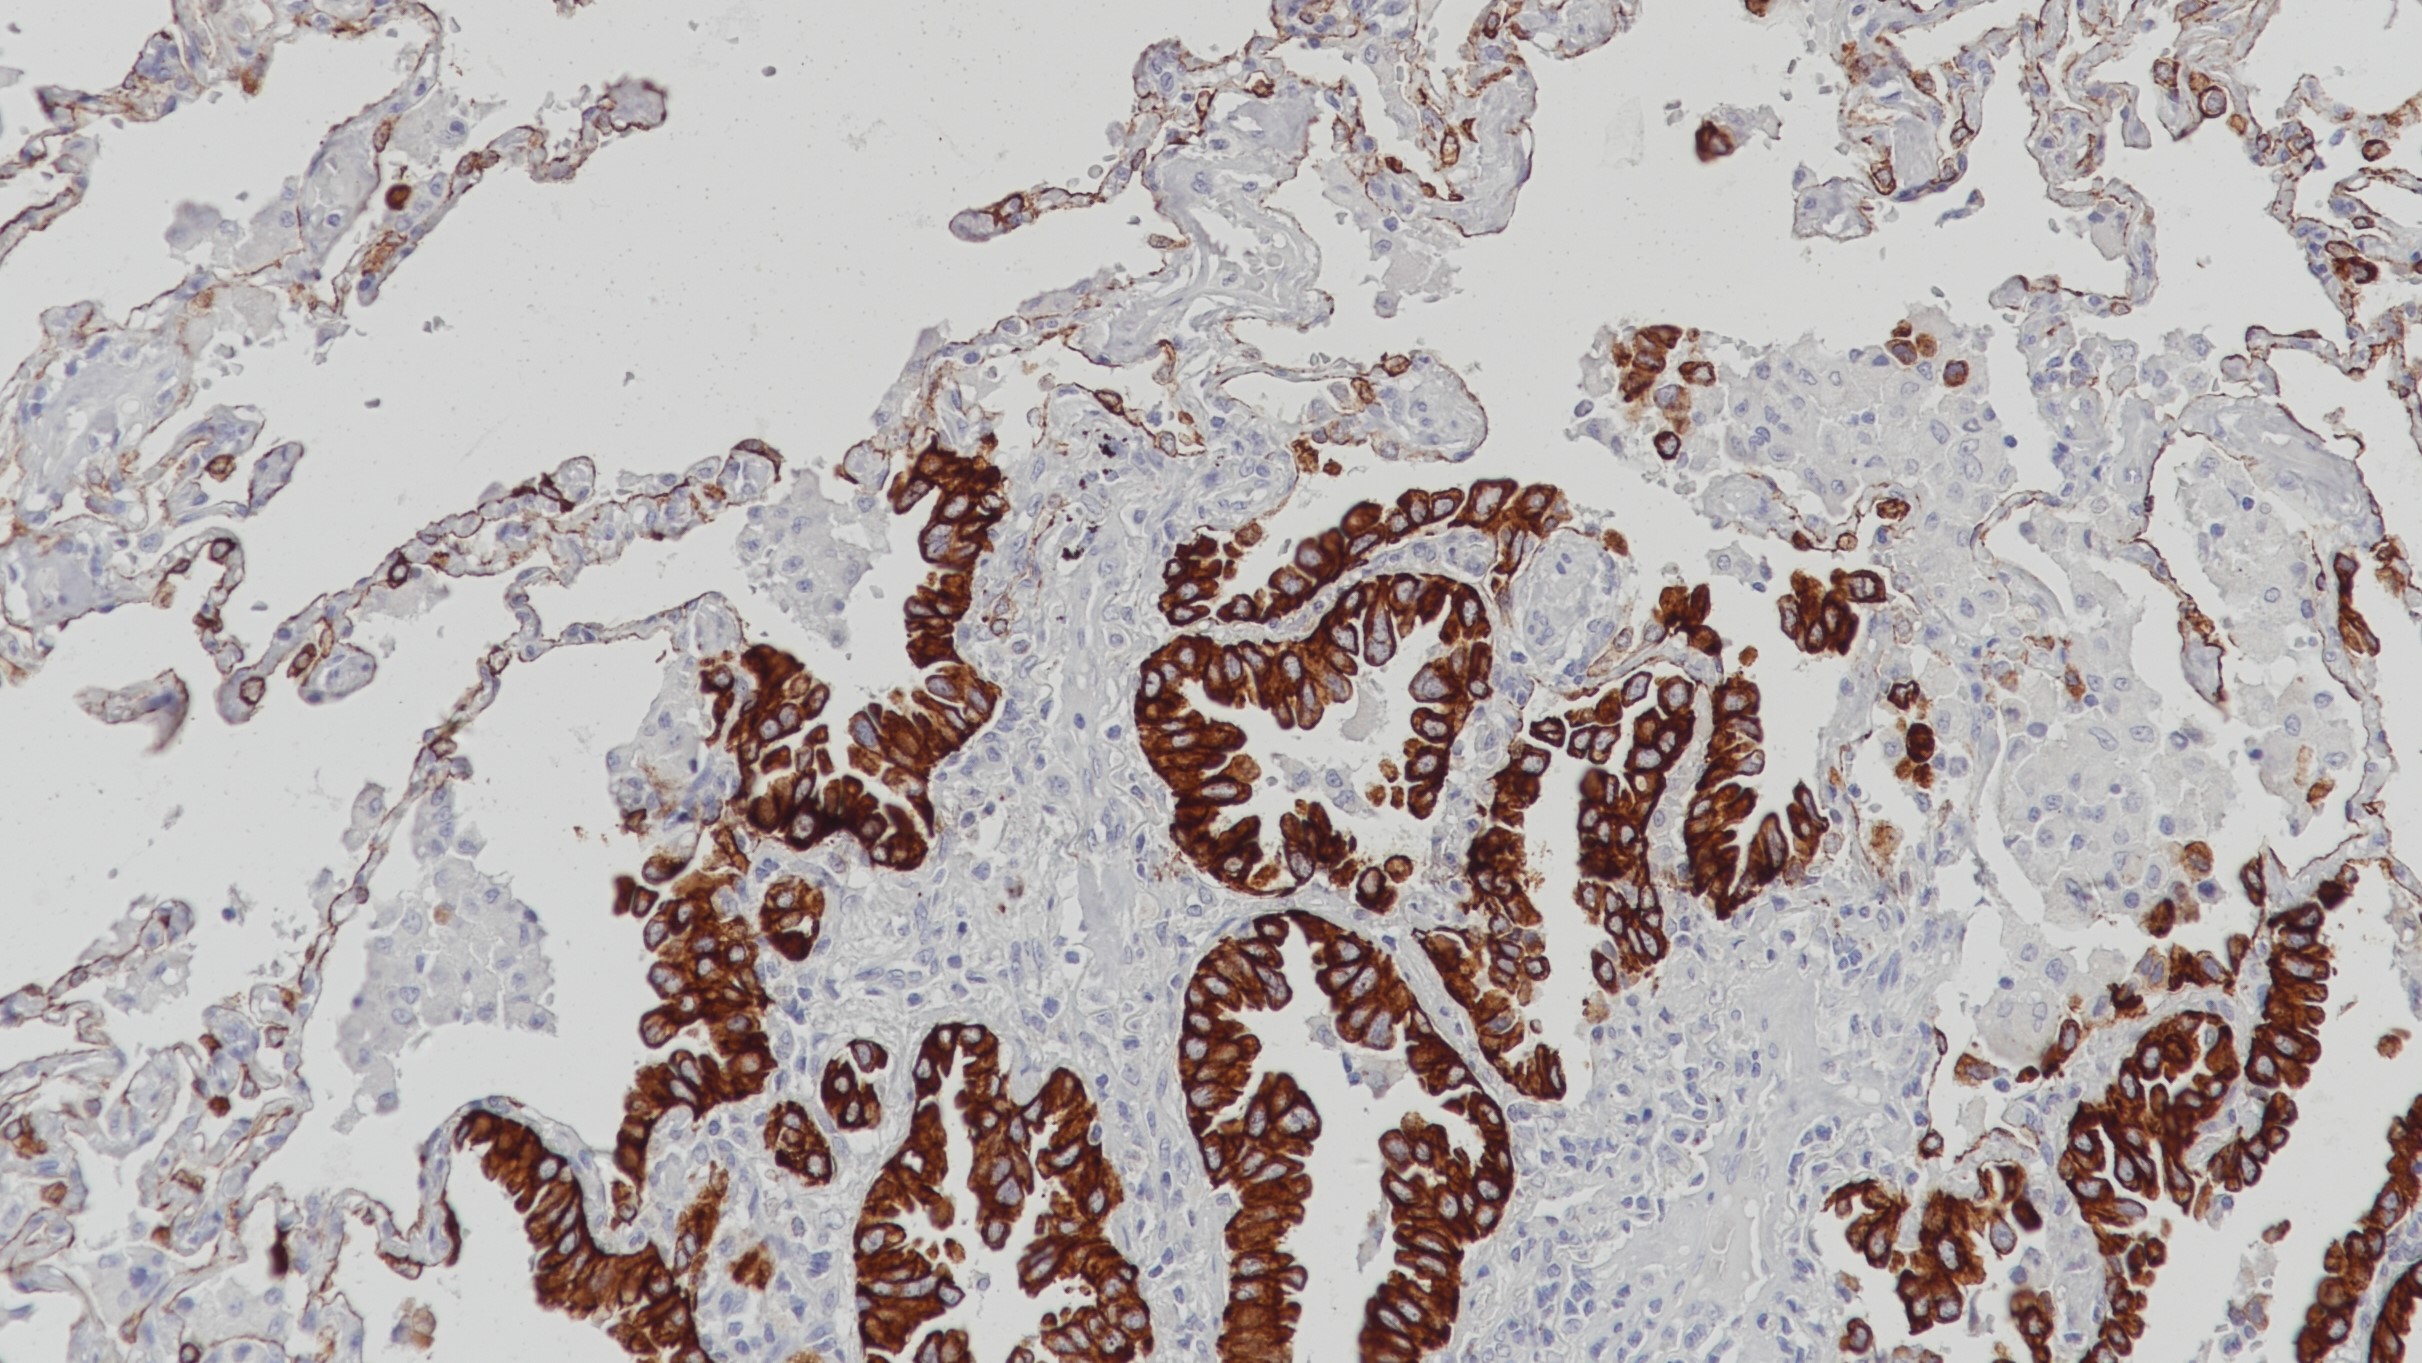
肺CK7(BP6060)染色

产品中心

肺腺癌CK7(BP6060)染色
肺CK7(BP6060)染色
Cytokeratin 7(CK7) 重组兔单克隆抗体
CK7是一种由KRT7基因编码合成的蛋白,通常和CK19成对出现。CK7在腺上皮和导管上皮中表达,如肺、乳腺、膀胱等,而在大部分消化道上皮、前列腺、肝细胞以及鳞状上皮中染色阴性。肿瘤组织中,大肠癌、前列腺癌以及鳞状上皮癌表现为CK7-。在临床上,CK7通常与CK20以及CDX-2一起用于卵巢癌、肺癌、乳腺癌(CK7+)以及大肠癌(CK7-)的诊断。
Specifications
- 产品注册名称
- 细胞角蛋白7抗体试剂(免疫组织化学)
- 目录号
- I1047
- 克隆号
- BP6060
- 亚细胞定位
- 细胞质
- 阳性对照
- 乳腺癌
- 修复方式
- HIER
- 组织类型
- FFPE
- 规格
- 工作液:1.5mL/7mL
浓缩液:0.1mL/1mL
- 用途
- NMPA IVD
CE
Applicable platform
- Biolynx平台
- Leica平台
- Roche平台
- Dako平台
Reference
1.Moll R, et al. Histochem Cell Biol. 2008 Jun;129(6):705-33.
2.Moll R, et al. Cell. 1982 Nov;31(1):11-24.


